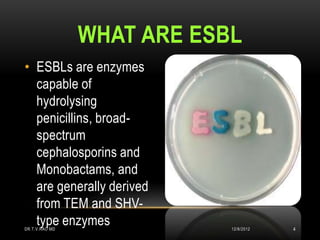
WHAT ARE ESBL
• ESBLs are enzymes
  capable of
  hydrolysing
  penicillins, broad-
  spectrum
  cephalosporins and
  Monobactams, and
  are generally derived
  from TEM and SHV-
  type enzymes
DR.T.V.RAO MD               12/8/2012   4
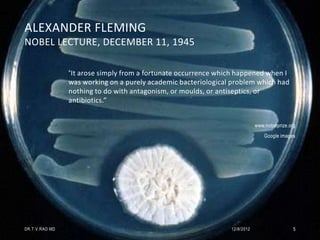
ALEXANDER FLEMING
NOBEL LECTURE, DECEMBER 11, 1945

                “It arose simply from a fortunate occurrence which happened when I
                was working on a purely academic bacteriological problem which had
                nothing to do with antagonism, or moulds, or antiseptics, or
                antibiotics.”


                                                                            www.nobelprize.org
                                                                                Google images




DR.T.V.RAO MD                                                   12/8/2012                    5
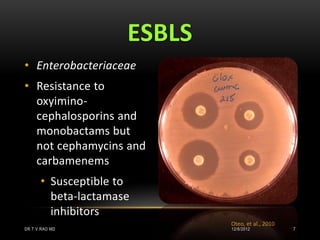
ESBLS
• Enterobacteriaceae
• Resistance to
  oxyimino-
  cephalosporins and
  monobactams but
  not cephamycins and
  carbamenems
      • Susceptible to
        beta-lactamase
        inhibitors
                             Oteo, et al., 2010
DR.T.V.RAO MD                12/8/2012            7
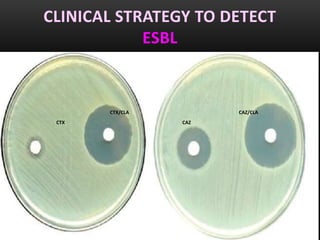
CLINICAL STRATEGY TO DETECT
            ESBL


       CTX/CLA         CAZ/CLA
 CTX             CAZ
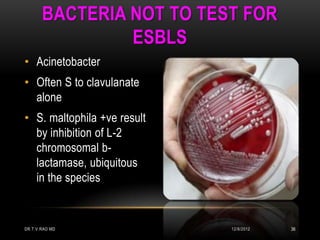
BACTERIA NOT TO TEST FOR
                ESBLS
• Acinetobacter
• Often S to clavulanate
  alone
• S. maltophila +ve result
  by inhibition of L-2
  chromosomal b-
  lactamase, ubiquitous
  in the species


DR.T.V.RAO MD                12/8/2012   36

This document discusses drug resistant gram-negative bacteria. It notes that there are currently no new drugs to treat infections from multidrug-resistant gram-negative bacilli such as Acinetobacter baumannii and Pseudomonas aeruginosa. It also discusses extended-spectrum beta-lactamases (ESBLs) which are enzymes produced by bacteria that confer resistance to many beta-lactam antibiotics. The document provides information on detecting and confirming ESBL production in bacteria.